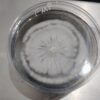
IMG_20260412_185338051~2

Fmp is a cubensis strain isolation from Thai Elephant Dung. It doesn’t have quite as large of fruits but it does have a very unique cap characteristic. The caps on these have a carmel color with darker colored stipes, resembling a tiger pattern.
Full Moon Party
Related products
Be the first to review “Full Moon Party” Cancel reply
You must be logged in to post a review.

Reviews
There are no reviews yet.